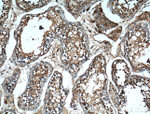
SERPINE2 Antibody in Immunohistochemistry (Paraffin) (IHC (P))

Search
Proteintech
SERPINE2 Monoclonal Antibody (1E11F12)
{{$productOrderCtrl.translations['antibody.pdp.commerceCard.promotion.promotions']}}
{{$productOrderCtrl.translations['antibody.pdp.commerceCard.promotion.viewpromo']}}
{{$productOrderCtrl.translations['antibody.pdp.commerceCard.promotion.promocode']}}: {{promo.promoCode}} {{promo.promoTitle}} {{promo.promoDescription}}. {{$productOrderCtrl.translations['antibody.pdp.commerceCard.promotion.learnmore']}}
产品信息
66203-1-IG
种属反应
宿主/亚型
分类
类型
克隆号
抗原
偶联物
形式
浓度
规格
纯化类型
保存液
内含物
保存条件
运输条件
产品详细信息
Immunogen sequence: EELGSNTGI QVFNQIVKSR PHDNIVISPH GIASVLGMLQ LGADGRTKKQ LAMVMRYGVN GVGKILKKIN KAIVSKKNKD IVTVANAVFV KNASEIEVPF VTRNKDVFQC EVRNVNFEDP ASACDSINAW VKNETRDMID NLLSPDLIDG VLTRLVLVNA VYFKGLWKSR FQPENTKKRT FVAADGKSYQ VPMLAQLSVF RCGSTSAPND LWYNFIELPY HGESISMLIA LPTESSTPLS AIIPHISTKT IDSWMSIMVP KRVQVILPKF TAVAQTDLKE PLKVLGITDM FDSSKANFAK ITTGSENLHV SHILQKAKIE VSEDGTKASA ATTAILIARS SPPWFIVDRP FLFFIRHNPT GAVLFMGQIN K (28-397 aa encoded by BC015663)
靶标信息
This gene encodes a member of the serpin family of proteins, a group of proteins that inhibit serine proteases. Thrombin, urokinase, plasmin and trypsin are among the proteases that this family member can inhibit. This gene is a susceptibility gene for chronic obstructive pulmonary disease and for emphysema. Alternative splicing results in multiple transcript variants.
仅用于科研。不用于诊断过程。未经明确授权不得转售。
生物信息学
蛋白别名: GDN; Glia derived nexin; Glia-derived nexin; glia-derived nexin precursor; Glia-derived nexin/protease nexin I; glial-derived neurite promoting factor; P17; Peptidase inhibitor 7; PI-7; plasminogen activator inhibitor type 1; PN-1; Protease nexin 1; Protease nexin I; protease nexin PN-1; serine (or cysteine) peptidase inhibitor, clade E, member 2; serine (or cysteine) proteinase inhibitor, clade E (nexin, plasminogen activator inhibitor type 1), member 2; serine (or cysteine) proteinase inhibitor, clade E, member 2; serine protease inhibitor 4; Serine protease-inhibitor 4; Serpin E2; serpin peptidase inhibitor, clade E (nexin, plasminogen activator inhibitor type 1), member 2; serpin peptidase inhibitor, clade E, member 2; SERPINE 2; unnamed protein product
基因别名: B230326M24Rik; GDN; GDNPF; Gdnpn1; PAI-1; PI-7; PI7; PN-1; PN1; PNI; SERPINE2; Spi4; Spin4
UniProt ID: (Human) P07093, (Rat) P07092, (Mouse) Q07235
Entrez Gene ID: (Human) 5270, (Rat) 29366, (Mouse) 20720